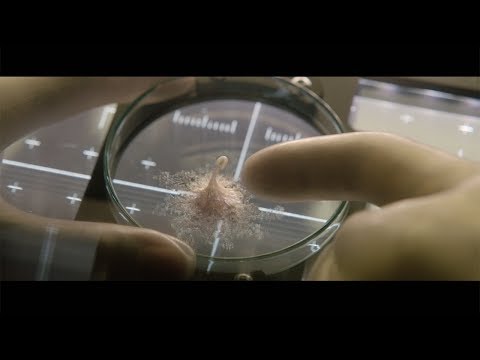

最新動画
一覧-
 11:02
11:02
志尊淳、現場で見せる優しいほほ笑み… 貴重な撮影の裏側公開 参天製薬「ヒアレインS」新ウェブ動画メーキング+インタビュー
再生= 0 -
 06:34
06:34
錦戸亮が弁護士役! 映画「ブルーボーイ事件」本編映像3種
再生= 81 -
 06:42
06:42
荒牧慶彦、恋愛リアリティショーに参加!? “カグヤ”を射止めようと各メンバーが自己PR 映画「プロジェクト・カグヤ」本編映像
再生= 101 -
 01:08
01:08
“殺人タックル”による謎の惨殺事件!? 吉田伶香が“スポ根ホラーラブコメ”で主演 映画「翔んだタックル大旋風」予告編
再生= 271 -
 01:01
01:01
「お終活」シリーズ第3弾 三田佳子&小日向文世がゲスト出演 映画「お終活3 幸春!人生メモリーズ」ティザー予告編
再生= 551 -
 01:01
01:01
市原隼人が主演 大分市を舞台にした心温まる物語 短編映画「デイズ~かけがえのない日々~」予告編
再生= 468 -
 02:47
02:47
MIYAVI「考えるきっかけに」 「難民映画祭」への思い吐露 石原さとみとオープニング上映イベントに登場
再生= 334 -
 02:16
02:16
石原さとみ、「難民映画祭」参加 きっかけは子供への切実な思い 子育てのために「私自身が変わらなければ」
再生= 673 -
 01:01
01:01
MEGUMIプロデューサー&濱尾ノリタカ主演「The Breath of the Blue Whale」予告/松田美由紀監督作「カラノウツワ」予告 【MIRRORLIAR FILMS Season8】
再生= 481 -
 02:23
02:23
のん、松重豊と刑事役に挑戦 張り込み中にフードデリバリー!? 「ロケットナウ」新CM「ゼロ配刑事篇」
再生= 2067 -
 03:21
03:21
DAIGO「まさにKTU」 9年ぶり『映画 きかんしゃトーマス』ゲスト出演 1歳息子のエピソードも
再生= 327 -
 04:39
04:39
佐藤二朗、受験生の父親役好演 坂元愛登が息子役 「カロリーメイト」受験生応援CM第12弾「いちばんの味方」編+メーキング
再生= 554

YouTubeでチャンネル登録
YouTubeでチャンネル登録



